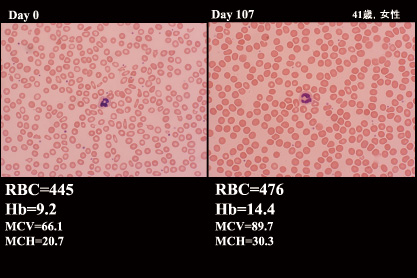

[緑陰随筆特集]
研修医時代の夏の思い出
|
|
東区・郡元支部
(デイジークリニック) 武元 良整
|
|
私は,昭和50年に鹿児島大学を卒業して,その当時,研修制度が確立されていた「川崎医大」で内科研修を受けました。
 |
図1 顕微鏡をのぞく
|
 |
図2 健康成人の末梢血液像
正常末梢血:Hb:14.5,MCV:89.0,MCH:31.0
|
医師になり,まず,3カ月間「循環器内科」の研修,続けて夏の暑い時期の7月から9月は「血液内科」の研修でした。それは夏らしいアウトドアの夏の思い出話ではなく,残念なことにインドアの涼しい話です。中央検査室の業務が終わる頃,夕方の検査室で毎日,一日のまとめとして顕微鏡の前に座り,オーベンから「血液像の見方」の指導を受けていました(図1)。懐かしく思い出すのはマンツーマンで指導医と相対して,双方から同じ末梢血液像を眺めて翌日の早朝回診に備えていた事。さすがに毎日のように白血病治療中の末梢血液像を観察するとその患者背景および治療全体の景色が見えてきて,標本1枚見る事で入院患者さんの名前が出てきます。実はこの研修医時代の夏の体験が現在の外来診療にとても役立っています。今では夏の良い思い出です。
私は,今,漢方内科と血液内科診療で開業して5年過ぎました。友人が開業時に「白血病の診療」はないだろうから,「貧血外来」をしたらどうだ?と勧めてくれ,おかげで「健診で貧血を指摘されて来院」という方々に漢方薬も駆使しながら,診療しております。
研修医の時,顕微鏡で末梢血液の小球性低色素性赤血球など観察していた経験から,貧血治療中の方にも「これがあなたの末梢血液像ですよ」といってその画像を見てもらうようにしています(図2)。一部の方はとても喜んで,治療継続の意欲が高くなり,貧血からの回復もかなり良好です。
図2は健康成人の末梢血液像です。一見してきれいな写真です。
図3は典型的な貧血症例です。小球性低色素性の赤血球が正球性正色素性の赤血球に入れ替わり(赤血球の寿命は約120日のため4カ月後に血液像は新しいものとなる),患者さんも貧血の回復には時間がかかっても納得の症例を以下に呈示します。
症 例:41歳女性。
主 訴:健診で貧血を指摘され来院,貧血の自覚症状なし。
婦人科:子宮筋腫なし。
経 過:鉄欠乏性貧血として,鉄剤内服3カ月半(Day 107)で写真(図3)のように正球性正色素性となりました。
鉄剤内服継続6カ月は貯蔵鉄(フェリチン)を正常化させるために必要な期間ですが,このようにHb(ヘモグロビン,血色素)の回復が良いと,治療による体調の回復を実感され,鉄剤の内服治療も可能です。
以上,研修医時代の夏の思い出として,わかりやすい末梢血液像を医師会員の先生方に紹介させていただきました。
皆様方も,鹿児島市医師会臨床検査センターへ血液生化学検査だけでなく,末梢血液像写真も依頼されると,鉄欠乏性貧血治療に興味が湧き,患者様の理解も深まる外来診療ができると思います。
|
| 図3 典型的な鉄欠乏性貧血,内服治療前後,Day 0とDay 107の赤血球像の比較 |

|
|
|
このサイトの文章、画像などを許可なく保存、転載する事を禁止します。
(C)Kagoshima City Medical Association 2016 |